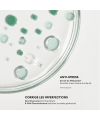
Soin anti imperfections ciblé stop boutons Patyka

- Nouveau
Patyka Soin ciblé Stop-Boutons - 15 ml
Soin anti-imperfections
Le soin ciblé Stop-Boutons Patyka cible et neutralise les boutons rapidement.
Pour qui : Les peaux mixtes à grasses sujettes aux imperfections.
Résultat : Un bouton visiblement réduit, apaisé et moins rouge en 24h.
Pourquoi on l’adore : Son action express et sa formule clean apaisent et corrigent sans agresser.
Départ le jour même pour toute commande passée avant 12h
Voir conditionsLivraison gratuite en France à partir de 65 € d'achat
Les retours sont facilités
Voir conditionsSans huile essentielle
 Enceinte ? En savoir plus
Enceinte ? En savoir plus
 Comédogène ? En savoir plus
Comédogène ? En savoir plus
Le soin ciblé Stop-Boutons Patyka est un traitement localisé flash anti-imperfections qui corrige, apaise et accélère la disparition des boutons en seulement 24h.
Les bienfaits
Réduit visiblement boutons rouges et blancs en 24h
Apaise les rougeurs et les sensations d’échauffement
Accélère la résorption des imperfections
Régule le sébum et limite la réapparition
Prévient les marques résiduelles
Idéal pour les peaux mixtes à grasses à tendance acnéique.
Ingrédients clés
Zinc gluconate : purifie et réduit l’excès de sébum
10% PHA (gluconolactone) : exfolie en douceur et désobstrue les pores
Centella Asiatica : répare, régénère et stimule le collagène
Acide glycyrrhétinique (réglisse) : apaise et réduit les rougeurs
Extrait de mélisse bio (breveté) : action anti-stress, réduit le cortisol cutané (-41%**)
Résultats cliniquement prouvés
-19% taille et rougeur du bouton en 24h*
88% des utilisateurs constatent un bouton neutralisé en 24h*
92% observent une réduction des boutons rouges et blancs*
88% trouvent leur peau apaisée en 24h*
*Tests cliniques et de satisfaction sur 24 sujets
99.9% du total est d'origine naturelle.
46,7% du total des ingrédients sont issus de l'Agriculture Biologique.
COSMOS ORGANIC certifié par Ecocert Greenlife selon le référentiel COSMOS.
INGRÉDIENTS : MENTHA VIRIDIS (SPEARMINT) LEAF EXTRACT*, AQUA (WATER), GLUCONOLACTONE, GLYCERIN, PENTYLENE GLYCOL, C15-19 ALKANE, TRIETHYL CITRATE, MICROCRYSTALLINE CELLULOSE, CETEARYL ALCOHOL, GLYCERYL STEARATE, ZINC GLUCONATE, SODIUM HYDROXIDE, MENTHYL LACTATE, GLYCYRRHETINIC ACID, CENTELLA ASIATICA EXTRACT*, ALOE BARBADENSIS LEAF JUICE POWDER*, MELISSA OFFICINALIS LEAF EXTRACT*, XANTHAN GUM, LEVULINIC ACID, SODIUM LEVULINATE, CELLULOSE GUM, TOCOPHEROL, CITRIC ACID, CARVONE**, SODIUM BENZOATE, POTASSIUM SORBATE, CHLOROPHYLLIN-COPPER COMPLEX [02-011-1.15]
*Ingrédients issus de l'Agriculture Biologique.
**Constituants naturels de la composition aromatique.
Cette liste d'ingrédients peut faire l'objet de modifications, veuillez consulter l'emballage du produit acheté.
Questions
Soyez le premier à poser une question sur ce produit !